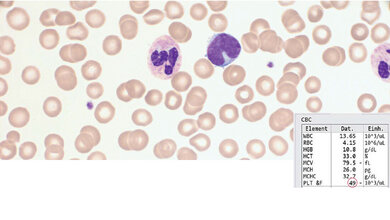
Immunthrombopenie bei einer Schwangeren

Typischerweise manifestieren sich HTP bereits im Säuglings- und Kindesalter. Je nach Art und Ausmaß des vorliegenden Gendefekts resultieren heterogene Krankheitsbilder mit unterschiedlich stark ausgeprägten klinischen Erscheinungsformen. Das Leitsymptom der HTP ist, abhängig vom Ausmaß der Thrombozytopenie, eine mehr oder weniger starke hämorrhagische Diathese. Meist liegt eine Bildungsstörung der Thrombozyten zugrunde, die auf einer Insuffizienz der Megakaryopoese im Knochenmark beruht. Je nach Art des zugrunde liegenden Gendefektes können Fehlbildungen des Skelettsystems hinzukommen sowie Bildungs- und/oder Funktionsstörungen der übrigen Zellreihen. Bei einem Teil der Erkrankungen ist die Thrombozytopenie kombiniert mit einer Thrombozytenfunktionsstörung (Thrombozytopathie). Dieser Beitrag gibt eine Übersicht zur Krankheitsgruppe der HTP.
DOI: 10.3238/MTADIALOG.2020.0458
Entnommen aus MTA Dialog 6/2020
Dann nutzen Sie jetzt unser Probe-Abonnement mit 3 Ausgaben zum Kennenlernpreis von € 19,90.
Jetzt Abonnent werden